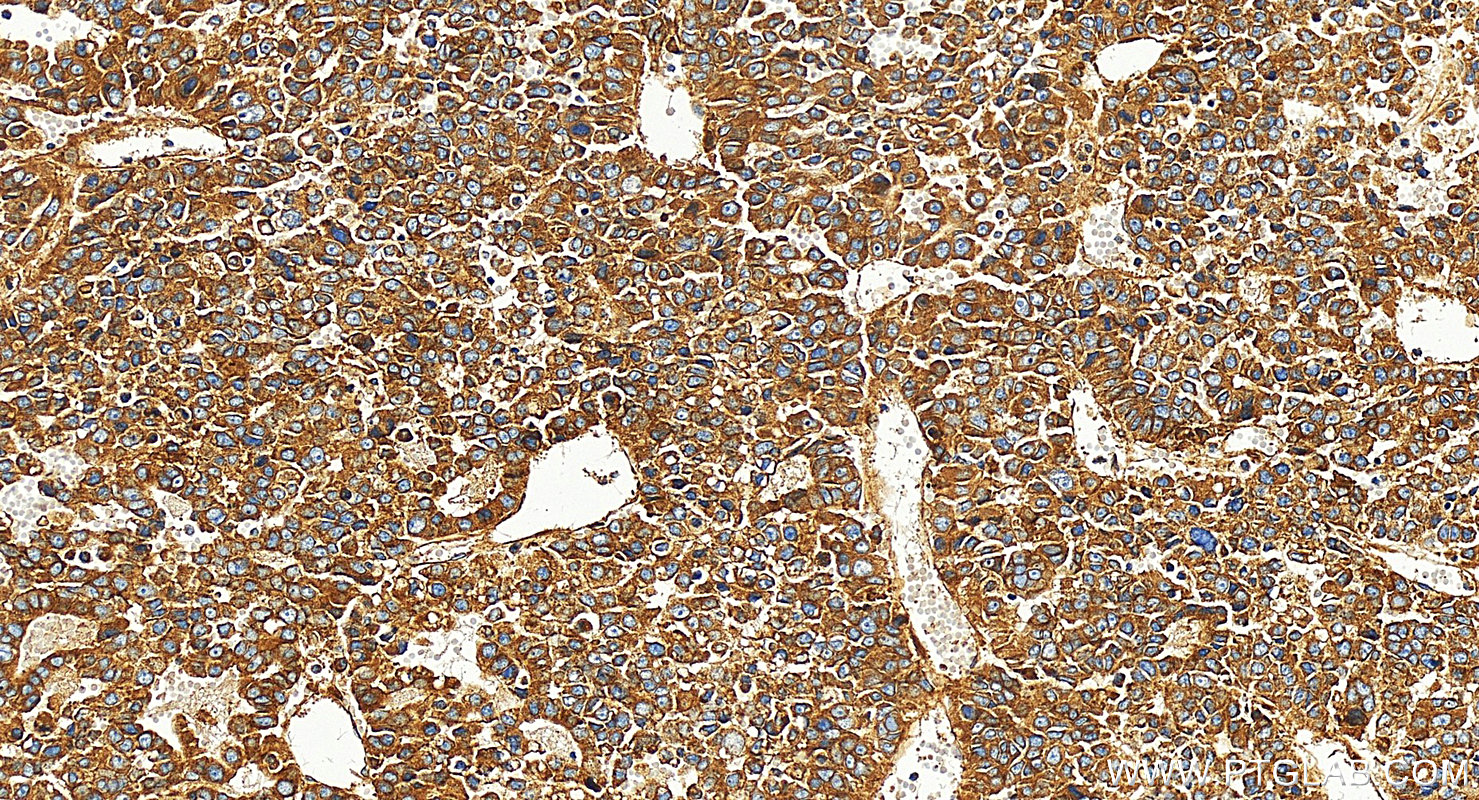
Immunohistochemistry (IHC) staining of human Hepatocellular carcinoma using Integrin Alpha V Polyclonal antibody (27096-1-AP)

Tested Applications
| Positive WB detected in | HUVEC cells, A549 cells, MCF-7 cells, human placenta tissue |
| Positive IHC detected in | human Hepatocellular carcinoma, human breast cancer tissue, human liver cancer tissue, human stomach cancer tissue Note: suggested antigen retrieval with TE buffer pH 9.0; (*) Alternatively, antigen retrieval may be performed with citrate buffer pH 6.0 |
| Positive IF/ICC detected in | A549 cells |
| Positive FC detected in | A549 cells |
Recommended dilution
| Application | Dilution |
|---|---|
| Western Blot (WB) | WB : 1:2000-1:10000 |
| Immunohistochemistry (IHC) | IHC : 1:500-1:2000 |
| Immunofluorescence (IF)/ICC | IF/ICC : 1:250-1:1000 |
| Flow Cytometry (FC) | FC : 0.25 ug per 10^6 cells in a 100 µl suspension |
| It is recommended that this reagent should be titrated in each testing system to obtain optimal results. | |
| Sample-dependent, Check data in validation data gallery. | |
Published Applications
| KD/KO | See 1 publications below |
| WB | See 19 publications below |
| IHC | See 4 publications below |
| IF | See 4 publications below |
Product Information
27096-1-AP targets Integrin Alpha V in WB, IHC, IF/ICC, ELISA applications and shows reactivity with human, mouse samples.
| Tested Reactivity | human, mouse |
| Cited Reactivity | human, mouse, rat |
| Host / Isotype | Rabbit / IgG |
| Class | Polyclonal |
| Type | Antibody |
| Immunogen |
CatNo: Ag25825 Product name: Recombinant human ITGAV protein Source: e coli.-derived, PGEX-4T Tag: GST Domain: 819-915 aa of BC136442 Sequence: SFSKAMLHLQWPYKYNNNTLLYILHYDIDGPMNCTSDMEINPLRIKISSLQTTEKNDTVAGQGERDHLITKRDLALSEGDIHTLGCGVAQCLKIVCQ Predict reactive species |
| Full Name | integrin, alpha V (vitronectin receptor, alpha polypeptide, antigen CD51) |
| Calculated Molecular Weight | 1048 aa, 116 kDa |
| Observed Molecular Weight | 130 kDa |
| GenBank Accession Number | BC136442 |
| Gene Symbol | Integrin alpha V |
| Gene ID (NCBI) | 3685 |
| RRID | AB_2880753 |
| Conjugate | Unconjugated |
| Form | Liquid |
| Purification Method | Antigen affinity purification |
| UNIPROT ID | P06756 |
| Storage Buffer | PBS with 0.02% sodium azide and 50% glycerol, pH 7.3. |
| Storage Conditions | Store at -20°C. Stable for one year after shipment. Aliquoting is unnecessary for -20oC storage. 20ul sizes contain 0.1% BSA. |
Background Information
Integrins are cell adhesion receptors that are heterodimers composed of non-covalently associated alpha and beta subunits. Integrin alpha V, also known as CD51, is a type I transmembrane glycoprotein composed of an extracellular domain, a transmembrane region and cytoplasmic domain (PMID: 2430295; 1690718). It can form heterodimers with one of the five beta integrin subunits (beta 1, 3, 5, 6, 8) that recognize ligands containing the sequence Arg-Gly-Asp, such as vitronectin, fibronectin, and osteopontin (PMID: 37087799). Integrin alpha V mainly plays a role in extracellular matrix-mediated cell adhesion and migration, differentiation, wound healing, inflammation, tumorigenesis, proliferation, angiogenesis, and metastasis.
Protocols
| Product Specific Protocols | |
|---|---|
| FC protocol for Integrin Alpha V antibody 27096-1-AP | Download protocol |
| IF protocol for Integrin Alpha V antibody 27096-1-AP | Download protocol |
| IHC protocol for Integrin Alpha V antibody 27096-1-AP | Download protocol |
| WB protocol for Integrin Alpha V antibody 27096-1-AP | Download protocol |
| Standard Protocols | |
|---|---|
| Click here to view our Standard Protocols |
Publications
| Species | Application | Title |
|---|---|---|
Aging Cell Fibronectin type III domain-containing 5 improves aging-related cardiac dysfunction in mice.
| ||
Curr Biol The viral restriction factor tetherin/BST2 tethers cytokinetic midbody remnants to the cell surface. | ||
Int J Mol Sci Macrophages Cytokine Spp1 Increases Growth of Prostate Intraepithelial Neoplasia to Promote Prostate Tumor Progression. | ||
Cell Signal C1GALT1 high expression enhances the progression of glioblastoma through the EGFR-AKT/ERK cascade | ||
Int J Mol Sci Identification of Novel microRNA Profiles Dysregulated in Plasma and Tissue of Abdominal Aortic Aneurysm Patients. |
Reviews
The reviews below have been submitted by verified Proteintech customers who received an incentive for providing their feedback.
FH Laura (Verified Customer) (08-28-2025) | It worked well with the protocol provided on the website
|
FH Alex (Verified Customer) (03-31-2025) | Exceptional focal adhesion staining in LN229 cells. Identity of the nuclear stain is unknown. Grayscale = Itgav antibody at 1:200. 4% formaldehyde fixation (methanol-free) with 0.1% Triton X-100 permeabilisation. Blocked in 2% BSA / 0.1% Triton X-100.
 |
FH Boyan (Verified Customer) (04-24-2019) | By WB, this antibody gave a clean band at the expected molecular weight; by IF, it could not label a specific pattern.
|